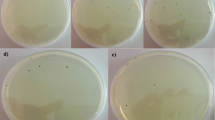

Abstract
The green oleaginous microalgae, Chlorella sorokiniana, is a highly productive Chlorella species and a potential host for the production of biofuel, nutraceuticals, and recombinant therapeutic proteins. The lack of a stable and efficient genetic transformation system is the major bottleneck in improving this species. We report an efficient and stable Agrobacterium tumefaciens-mediated transformation system for the first time in C. sorokiniana. Cocultivation of C. sorokiniana cells (optical density at λ680 = 1.0) with Agrobacterium at a cell density of OD600 = 0.6, on BG11 agar medium (pH 5.6) supplemented with 100 μM of acetosyringone, for three days at 25 ± 2 °C in the dark, resulted in significantly higher transformation efficiency (220 ± 5 hygromycin-resistant colonies per 106 cells). Transformed cells primarily selected on BG11 liquid medium with 30 mg/L hygromycin followed by selecting homogenous transformants on BG11 agar medium with 75 mg/L hygromycin. PCR analysis confirmed the presence of hptII, and the absence of virG amplification ruled out the Agrobacterium contamination in transformed microalgal cells. Southern hybridization confirmed the integration of the hptII gene into the genome of C. sorokiniana. The qRT-PCR and Western blot analyses confirmed hptII and GUS gene expression in the transgenic cell lines. The specific growth rate, biomass doubling time, PSII activity, and fatty-acid profile of transformed cells were found similar to wild-type untransformed cells, clearly indicating the growth and basic metabolic processes not compromised by transgene expression. This protocol can facilitate opportunities for future production of biofuel, carotenoids, nutraceuticals, and therapeutic proteins.
Similar content being viewed by others
Avoid common mistakes on your manuscript.
Introduction
Oil-rich microalgae are fast emerging as an alternative source of lipids/triacylglycerols (TAGs) for large-scale biodiesel production due to their ability to produce large biomass and lipids cells without competing for arable land (Zienkiewicz et al. 2016). Their capacity to recycle atmospheric CO2 through high photosynthetic efficiency, sequester greenhouse gases, absorb nutrients from wastewater, store significant amounts of starch for effective utilization in ethanol production and biosynthesis of high-value bioactive metabolites have attracted increased attention (Shaikh et al. 2019). Microalgae endure adverse environmental conditions owing to TAGs, the typical lipids with a storage function in the cells (Sharma et al. 2012). Despite having numerous advantages in biofuel and biorefinery production, the inherent low growth rate of oleaginous microalgae poses the biggest obstacle in its use as biofuel feedstock (Pribyl et al. 2012). Nutrient availability (Courchesne et al. 2009), light- and temperature-dependent growth (Randhawa et al. 2017), and stress-inducible lipid accumulation (Shaikh et al. 2019) in microalgal cells impose additional constraints in their utilization for commercial-scale production of biofuel and bio-commodities. Finding high biomass-producing algal strains with metabolic routes for carbon allocation to TAGs is essential to sustainable biofuel production (Pribyl et al. 2012). Improving lipid content in the wild strains of microalgae through genetic regulation of TAG biosynthesis could boost these strains' potential use for biofuel production (Zhu et al. 2016).
The oleaginous microalgae, Chlorella sorokiniana, is a highly productive species among the most studied microalgae genus, Chlorella, as identified by various consortiums (Rosenberg et al. 2014; Barry et al. 2015; de Andrade and de Andrade 2017). The species of the Chlorella genus of green algae (Chlorophyceae), with both photoautotrophic and heterotrophic mode of growth, are widely utilized for production of nutritional supplements (Cordero et al. 2011), bioremediation (Naidoo et al. 2019), and as a model organism for studying basic knowledge on microalgal physiology and metabolism (Rosenberg et al. 2014). Among various Chlorella species, the whole genome of C. sorokiniana is fully sequenced, annotated, and publicly available allowing comparative genomics study for biofuel applications (https://greenhouse.lanl.gov/greenhouse/organisms). Genome sequencing and annotation projects have enabled the reconstruction of metabolic pathways, and widespread use of RNA-Seq methods has allowed a more accurate prediction of microalgal metabolisms (Merchant et al. 2012). The recent development in functional analysis of genes involved in TAG biosynthesis and photosynthesis (Courchesne et al. 2009), expressed sequenced tag (EST) databases, prediction of de novo chloroplast TAG biosynthesis (Zienkiewicz et al. 2016), and information on transcription factors involved in these cellular metabolisms has brought new opportunities to harness the benefits of algal biotechnology (Bajhaiya et al. 2017). Thus, it is necessary to develop a reliable DNA transfer method in microalgae to improve the wild strains, understand basic metabolic processes underpinning growth, photosynthesis, and oil biosynthesis, and the production of high-value bioactive metabolites and recombinant proteins (Ng et al. 2017). However, except for a few model algae (Mini et al. 2018) and diatoms (Han et al. 2020), the method of introducing DNA into eukaryotic microalgae is still far from routine (Sharma et al. 2018).
A variety of transformation methods have been employed to transfer foreign DNA into microalgal cells (Radakovits et al. 2010), involving electroporation (Lee et al. 2020), biolistic (George et al. 2020), and Agrobacterium-mediated gene transfer (Dehghani et al. 2020), however, the progress is mostly confined to the model alga, Chlamydomonas reinhardtii (Doron et al. 2016). The electroporation and biolistic gene transfer methods have their drawbacks, including potential cell damage and often transferring multiple copies of the transgene. Among the DNA transfer methods, Agrobacterium-mediated gene transfer is the most preferred method due to its ability to transfer low copies of the transgene and integrate foreign DNA preferentially into transcriptionally active genomic regions and feasibility to transfer large DNA segment with minimal rearrangement. Most importantly, the procedure is inexpensive and straightforward (Bakshi et al. 2011). However, only a few microalgal species have been successfully transformed by the Agrobacterium-mediated gene transfer method, which includes the model alga, C. reinhardtii (Kumar et al. 2004; Pratheesh et al. 2014; Mini et al. 2018), and the non-model algal species H. pluvialis (Kathiresan et al. 2009), Isochrysis sp. (Prasad et al. 2014), C. vulgaris (Cha et al. 2012), Dunaliella (Srinivasan and Gothandam 2016), Scenedesmus acutus (Suttangkakul et al. 2019) and C. sorokiniana (Gomez-Espinoza et al. 2018). However, in C. sorokiniana, the published methods (Gomez-Espinoza et al. 2018) lacked the confirmation of stable transgene integration by Southern hybridization and recombinant protein. For the first time, we report a method for stable Agrobacterium-mediated transformation in C. sorokiniana and crucial parameters (type of cocultivation medium, acetosyringone concentration, and co-culture duration) influencing efficient gene transfer.
Materials and methods
Strain and growth conditions
C. sorokiniana (strain CG12) used in this study was collected from Prof. Vaibhav V. Goud (Center for Energy, IIT Guwahati, India). The strain was maintained as axenic cultures in liquid and solid BG11 medium (Stanier et al. 1971) and TAP medium (Sueoka 1960). The cultures were maintained at 25 °C under a 16-h light/8-h dark photoperiod regime (50 ± 5 μmol photons m−2 s−1) in an orbital shaker (120 rpm). Microalgal growth rates were measured by absorbance at 680 nm (OD680) and gravimetrically by measuring the dry cell weight (DCW).
The binary vector pCAMBIA1301 (GeneBank accession: AF234297.1) containing a β-glucuronidase (gusA) as reporter and hygromycin phosphotransferase II (hpt II) gene as a selectable marker, both driven by CaMV35S promoter was used in this study. The binary vector was mobilized into A. tumefaciens strain EHA105 using the tri-parental mating procedure (Wise et al. 2006). The A. tumefaciens strain EHA105 harboring pCAMBIA1301 was maintained on yeast extract peptone (YEP) agar plates (pH 7.2) containing rifampicin (20 mg/L) and kanamycin (50 mg/L).
Antibiotic sensitivity assay
The minimum inhibitory concentration of hygromycin was determined by plating 1 × 105 cells of C. sorokiniana CG12 cells onto solid/liquid BG11 media supplemented with varying concentrations of hygromycin (0, 15, 30, 45, 60, and 75 mg/L), and the whole assay was repeated in triplicates. The freshly inoculated cultures were incubated in the dark for two days at 25 °C before exposure to light, and the number of surviving colonies was accessed after 15 days.
Agrobacterium-mediated transformation of C. sorokiniana
For transformation experiments, Agrobacterium cells at early log-phase were used. A single bacterial colony was inoculated into 10 ml (mL) of liquid YEP medium supplemented with appropriate antibiotics and grown overnight at 28 °C in a shaker incubator at 180 rpm until OD600 reached 1.0. The bacterial cells were collected by centrifugation at 4500×g for 5 min in 50 mL falcon tubes. The supernatants were carefully decanted, and the pellets were resuspended in 20 mL of liquid BG11 or TAP medium to maintain the final OD600 of Agrobacterium culture at 0.6. For virulence gene induction, acetosyringone (50–200 μM) was added to the Agrobacterium culture medium (BG11 or TAP) media, and incubated at 28 °C for 1 h with gentle shaking.
Prior to cocultivation, 1 × 106 cells/mL of C. sorokiniana culture from log-phase culture were plated onto BG11/TAP-agar media and precultured for a week at 25 °C. The cells were harvested and subsequently washed twice with the induction medium (BG11/TAP medium + 50 to 200 μM acetosyringone) on the day of cocultivation. After washing, the algal cells were finally resuspended in 1 mL of induction medium containing Agrobacterium cells and incubated at 28 °C for 30 min with mild agitation. The cell suspension was then spread onto the induction medium solidified with 1.2% (w/v) agar. Cocultivation was performed for 24–72 h at 25 °C in the dark. Following cocultivation, cells were harvested with BG11 liquid medium supplemented with cefotaxime (500 mg/L) and incubated in the dark at 25 °C for two days to eliminate Agrobacteria. The algal cells were then collected and washed twice with ddH2O by centrifugation at 4500×g for 5 min. The transformed algal cell pellet was resuspended into 5 mL of liquid selection media (BG11 containing 30 mg/L hygromycin) containing 500 mg/L cefotaxime and incubated at 25 °C in the dark for two days before transferring to light conditions for five more days. After this step, 100 µL of the homogenous cell suspension was inoculated into 5 mL of fresh BG11 liquid selection medium and incubated at 25 °C in light conditions for seven days. Subsequently, this step was repeated five times before plating the positively selected cells onto agar-selection medium (75 mg/L hygromycin) to isolate individual resistant colonies. Resistant colonies were randomly selected and propagated on a non-selective TAP medium for 12 days. The possibility of Agrobacterium contamination in the putatively transformed lines was checked by observing the growth of Agrobacterium on the YEP medium, inoculated with 100 µL of transformants grown from TAP media (Fig. S1). In addition to visual observation, the possibility of Agrobacterium contamination was checked by PCR amplification of the VirG internal region.
Optimization of cocultivation parameters
The effect of three cocultivation parameters known to influence transformation efficiency namely, cocultivation duration (1, 2, and 3 days), type of cocultivation media (BG11 and TAP), and acetosyringone concentration (50, 100, 150, and 200 μM) was evaluated.
The effect of each cocultivation parameter on the transformation efficiency was studied by varying one parameter at a time while keeping others constant. The transformation efficiency was calculated based on the numbers of hygromycin-resistant colonies per 106 starting cells, as described by Suttangkakul et al. (2019). Each parameter was tested in triplicates. The data were subjected to analysis of variance (ANOVA) and mean separation by Duncan’s multiple range test (DMRT) using a single-factor utterly randomized block design to study the effect of different treatments on the transformation frequency.
PCR detection of C. sorokiniana transformants
Genomic DNA from transformed and wild-type (WT) C. sorokiniana was isolated using CTAB method (Murray and Thompson 1980). PCR analysis was carried out to detect the presence of hptII using hptII gene-specific primers (Table S1).
Southern blotting
Randomly selected PCR-positive C. sorokiniana transformants were further analyzed by Southern hybridization to stabilize the T-DNA's stable integration. For confirmation of the transgene's stability, the transgenic cultures were subsequently propagated in standard TAP medium up to nine times, and then genomic DNA (gDNA) of the transformants was extracted. The gDNA was isolated from 2 g (wet cell weight) of transgenic and control wild-type cells using the NucleoSpin Plant II Maxi kit (Macherey–Nagel, Duren, Germany). Approximately 100 µg of genomic DNA was digested with PstI or HindIII. The digested samples were separated on a 0.6% agarose gel and transferred onto a positively charged Zeta-Probe nylon membrane (Bio-Rad, USA) using a vacuum-assisted blotting procedure (Gross et al. 1988). The blot was hybridized with a DIG-labeled 0.5-kb PCR product, corresponding to the coding region of the hptII gene. Pre-hybridization and hybridization were carried out using high hybridization buffer containing 5XSSC, 1% blocking solution, 0.1% (w/v) N-lauroyl sarcosine and 0.02% (w/v) sodium dodecyl sulfate. Washing and detection were carried out according to the instruction of the DIG-labeling and detection system (Roche Applied Science, Mannheim, Germany).\
Detection of hptII and gus gene expression
Quantitative Real-time PCR (qRT-PCR) was performed to examine the expression of the hptII. RNA was isolated using Trizol (Invitrogen, USA), and 1 μg of total RNA was used for the cDNA synthesis using a reverse transcription kit (Thermo Scientific, USA). For qRT-PCR, primers for hptII were used (Table S1). Actin primer CsAct1 was used as an internal control. The relative fold-change in the hptII transcript was estimated by the comparative ΔΔCT method (Pfaffl 2006; Schmittgen and Livak 2008). The corresponding standard errors were computed as described by Hoebeeck et al. (2007).
Western blotting was carried out to detect the expression of gus gene. Total protein was extracted from freshly harvested algae following the procedure described by Weis et al. (2002). Protein concentrations were assessed using the Bradford protein assay (He 2011). Equal amounts of protein were loaded onto a 12% SDS-PAGE gel and electrophoresed on a Hoefer SE 260 gel unit (GE Healthcare, USA) at room temperature. The total proteins separated by SDS-PAGE were electrotransferred to polyvinylidene difluoride membrane (GE Healthcare, Freiburg, Germany) and blocked with 3% BSA in TBST buffer (20 mM Tris–HCl, 120 mM NaCl, 0.1% Tween 20) for two hours. The membrane was probed with polyclonal primary antibodies (AB clonal Technology, Woburn, MA, USA) against the GUS protein at 4 °C for 12 h. Following the washing, the blot was incubated with HRP-labeled secondary antibodies (Sigma-Aldrich, Darmstadt, Germany) for two hours. The blots' signals were detected using the Super Signal West Dura Trial Kit (Thermo Scientific, IL, USA).
Cell growth kinetics and photosystem II (PSII) activity
Growth kinetics parameters such as specific growth rate (μ) and cell doubling time (dt) were analyzed as described by Godoy-Hernandez and Vázquez-Flota (2006). Calculation of the growth parameters was made with the Eqs. (1) and (2):
where X0 is the initial cell density, and X is the cell density at time t.
Photosynthetic activities of transformed microalgal cells were determined by non-invasive fluorescence measurements using a DUAL-PAM100 Chlorophyll Fluorometer (Heinz Walz Gmbh, Effeltrich, Germany). Aliquots of dark-adapted cultures (1 mL) were used for analyzing three primary fluorometric parameters, the maximum photochemical yield of PSII (Fv/Fm), effective PSII photochemical yield (YII), and Relative electron transport rate through PS II (rETR). All the readings were taken in triplicates, as described by Malapascua et al. (2014).
Analysis of neutral lipid and fatty acids in C. sorokiniana transformants
Total lipids were isolated following the method described by Bligh and Dyer (1959). Approximately, 100 mg (DCW) of microalgal cells was used for the extraction of total lipids and the subsequent analysis of neutral lipid and fatty-acid (FA) profiles (Maravi et al. 2016). The isolated lipids were fractionated by thin-layer chromatography and were resolved using hexane: diethyl ether: acetic acid (70:30:1, v/v/v) solvent system. Analysis of the FA profile of the C. sorokiniana transformants was done by Gas chromatography (GC). Before GC analysis, KOH/methanol-based derivatization of the lipids to methyl esters was done. The peaks were annotated based on their retention times compared to a reference FAME mixture (Supelco, Bellenfonte, PA, USA). FA profile was calculated based on the peak area percentage of total fatty acids.
Results and discussion
Optimization of the selection conditions for C. sorokiniana transformation
Determining the sensitivity of a microalgal species to a particular antibiotic is crucial for selecting microalgal cells transformed with an antibiotic selection marker gene. The growth of wild-type C. sorokiniana cells at the exponential phase was tested for their sensitivity to hygromycin on BG11 agar medium supplemented with 0–75 mg/L hygromycin (Fig. 1a) and BG11 liquid medium supplemented with 0–30 mg/L hygromycin (Fig. 1b) after determining the optimum hygromycin concentration on BG11 agar plate. After 15 days of culture on hygromycin-containing medium, the growth of C. sorokiniana cells was determined. The lowest hygromycin concentration that completely inhibited C. sorokiniana cells' growth in BG11 agar medium was 75 mg/L and 30 mg/L in liquid BG11 medium (Fig. 1a, b). Therefore, BG11 liquid medium with 30 mg/L hygromycin was used for primary selection, and BG11 agar medium with 75 mg/L hygromycin was used for subsequent selection of homogenous transformants.
Agrobacterium-mediated transformation of C. sorokiniana
The binary vector pCAMBIA1301 harboring the hptII gene as a selection marker and gus reporter was mobilized to A. tumefaciens vir helper strain EHA105. A single clone of recombinant A. tumefaciens was used for the transformation of C. sorokiniana. Preliminary experiments were carried out prior to large-scale transformation for establishing efficient Agrobacterium-mediated transformation for C. sorokiniana.
In earlier studies, A. tumefaciens showed the ability to transform different microalgae (Naing et al. 2016; Karami 2008; Rathod et al. 2013; Cha et al. 2012). However, the transformation efficiency of different recipient cell types does not show the same consistency. The choice of cocultivation conditions mainly, cocultivation duration, type of cocultivation media, and acetosyringone concentration, greatly determine the transformation efficiency. Hence, it is crucial to standardize the cocultivation conditions to design a reliable and efficient gene delivery system. In this study, three crucial cocultivation parameters were evaluated, which included the type of cocultivation media (BG11 and TAP), cocultivation duration (1, 2, and 3 days), and acetosyringone concentration (50, 100, 150, and 200 μM).
Based on previous literature, cocultivation was performed on solid media as T-DNA transfer was not successful in liquid media (Cha et al. 2012). When cocultivation was carried out on BG11 agar media, it produced the most number of transformed colonies compared to on TAP-agar media (Fig. 2). On the contrary, TAP media in both cocultivation and the selection stage have resulted in higher transformation efficiency in model microalgae (Kumar et al. 2004; Mini et al. 2018; Anila et al. 2011). Based on our results, BG11 media was selected as the cocultivation medium for C. sorokiniana transformation.
Effect of different cocultivation parameters on the transformation efficiency in C. sorokiniana. The tested cocultivation conditions include type of cocultivation media (BG11 and TAP), acetosyringone concentrations (A: 50 μM; A: 100 μM; A: 150 μM; and A: 200 μM), and cocultivation periods (24 h, 48 h, and 72 h). The difference between each of the instances tested for the different cocultivation conditions was significant at P < 0.05 by Tukey test, where values represented as mean ± SD (n = 3)
The cocultivation period is one of the crucial parameters that influence the transformation efficiency (Naing et al. 2016; Cha et al. 2012), and the optimal duration of cocultivation is dependent on the Agrobacterium strain, host cell type, and the cocultivation medium (Barik et al. 2005; Kumar et al. 2012; Hu et al. 2006). The highest number of hygromycin-resistant colonies was observed after three days of cocultivation (Fig. 2). This observation was similar with previous findings wherein three days of cocultivation was optimal for the transformation of Chlorella (Cha et al. 2012), Isochrysis (Prasad et al. 2014), and C. reinhardtii (Pratheesh et al. 2014).
Our results indicated that Agrobacterium-mediated transformation of C. sorokiniana was optimal when cocultivation medium was supplemented with 100 µM of acetosyringone as the number of transformed colonies dramatically increased with an increase in acetosyringone concentration from 50 to 100 µM (Fig. 2). Further increase in acetosyringone concentration above 100 µM did not appear to increase the transformation efficiency. Phenolic compounds such as acetosyringone are known to induce Agrobacterium virulence and stimulate bacterial surface attachment to the host cells, thereby enhancing the transformation efficiency (Naing et al. 2016; Karami 2008). Interestingly, the transformation of certain microalgal species, such as Chlamydomonas (Kumar et al. 2004), Haematococcus (Kathiresan et al. 2009), and Parachlorella kessleri (Rathod et al. 2013), was possible without the inclusion of acetosyringone. However, a study in Chlorella reported that T-DNA transfer was not feasible in the absence of acetosyringone (Cha et al. 2012), while a high concentration of acetosyringone negatively affected transformation efficiency (Chakrabarty et al. 2002; Zhu et al. 2009). The optimal acetosyringone thus depends on the microalgal species, cocultivation media, and cocultivation duration. Our results revealed that the cocultivation of C. sorokiniana cells (OD680 = 1.0) on BG11 agar medium with pH 5.6, supplemented with 100 μM of acetosyringone, for three days at 25 ± 2 °C in the dark, with Agrobacterium at a cell density of OD600 = 0.6 yielded the best result. Our method's transformation efficiency was determined to be 220 ± 5 colonies per 106 cells, significantly more efficient than the previous report described for other Chlorella species (Sanitha et al. 2014).
PCR analysis of putative C. sorokiniana transformants
Two putative hygromycin-resistant C. sorokiniana colonies were randomly selected and cultured on liquid BG11 medium containing 500 mg/L cefotaxime to eliminate Agrobacterium contamination. Genomic DNA was extracted from the putative transformants and subsequently subjected to PCR analysis (Fig. 3a). Expected amplification of a 500 bp DNA fragment with hptII specific primers (Table S1) in each of the transformants analyzed confirmed the presence of hptII in the genome of C. sorokiniana transformants (Fig. 4c). No amplification was observed in the wild-type cell lines.
Tolerance of wild-type and transgenic lines of C. sorokiniana against hygromycin in (A) BG11 liquid media with hygromycin (30 mg L−1): wild-type cells under hygromycin selection [Wt(+ hyg)] and without hygromycin selection [Wt(−hyg)], Transgenic cell lines under hygromycin selection [CsTr-9(+ hyg) and CsTr-16(+ hyg)]. (B) PCR amplification of the 350 bp-fragment of VirG gene for the detection of Agrobacterium contamination in the transgenic cell lines of C. sorokiniana: lane M, molecular marker; lane Wt, wild type; lane CsTr-9/16; transgenic lines; lane + Ve, Agrobacterium strain EHA105 (positive control);lane −ve, negative control
Molecular analysis to detect transgenic lines of C. sorokiniana. a Southern blot hybridization of PstI and HindIII digested genomic DNA of wild-type (Wt) and transgenic lines (CsTr-9/16) of C. sorokiniana hybridized to the hptII probe; lane + Ve, HindIII digested pCAMBIA1301 (11 Kb); b T-DNA region of pCAMBIA1301 binary vector used for transformation experiment; c PCR amplification of 634 bp-fragment of hptII gene; lane M, molecular Marker; lane CsTr-9/16, transgenic lines; lane Wt, wild type; lane + Ve, positive control; lane −Ve, negative control; d Transcript abundance of hptII gene in C. sorokiniana transformants. Expression analysis was carried out by semi-quantitative PCR using actin as an internal control (e); f Quantitative RT-PCR for analysis of relative abundance of hptII transcripts; g Western blot of C. sorokiniana transformants (CsTr-9 and CsTr-16) and wild-type (Wt.) cell lines; lane + Ve, positive control (GUS protein)
Detection of Agrobacterium contamination in the transformants
The possibility of Agrobacterium contamination in the transgenic lines was checked by observing the growth of Agrobacterium in YEP medium inoculated with transformed C. sorokiniana culture (Fig. S1). As the growth rate of Agrobacteria tends to be faster than that of microalgae, this preliminary test helped to check the bacterial contamination in microalgal cultures (Srinivasan and Gothandam 2016; Prasad et al. 2019). No bacterial growth was observed in the cultures inoculated with the two transformed microalgal cultures viz, CsTr-9 and CsTr-16, even after 48 h of incubation at 28 °C. Both of the transformants were also assessed by PCR analysis using virG-specific primers to rule out bacterial contamination. No amplification of virG was detected in the C. sorokiniana transformed cultures (Fig. 3b), revealing the absence of Agrobacterium contamination within the transformants (CsTr-9 and CsTr-16). This result also supported the fact that the hptII PCR analysis of the transgenic cell lines showed that there are no Agrobacterium cells containing pCAMBIA 1301 plasmid in the transgenic C. sorokiniana cultures.
PCR-based detection of marker genes located in the non-T-DNA region of the Ti-plasmid or virC/virG (virulence) genes that lie in the Agrobacterium resident vir helper plasmid is, therefore, a good indicator for the presence of Agrobacterium contamination. Previous studies on Agrobacterium-mediated transformation of various microalgae such as P. purpureum (Prasad et al. 2019), C. reinhardtii (Mini et al. 2018), Dunaliella salina (Srinivasan and Gothandam 2016) have shown PCR-based detection of non-T-DNA localized npt or virC/virG to check the presence of Agrobacterium DNA in the transformed cultures.
Southern hybridization analysis for T-DNA integration
Southern hybridization analysis determined the stable integration of the transgene into the nuclear genome of PCR-positive C. sorokiniana transformants. The two C. sorokiniana transformants showed signals corresponding to hybridization with hptII, indicating stable T-DNA integration with single transgene copy insertion. The different hybridization patterns observed for two different restriction enzymes indicated random integration of the T-DNA into the genome (Fig. 4a). No hybridization signal was detected in wild-type C. sorokiniana cells.
Expression analysis of hptII in C. sorokiniana transformants
The relative expression of hptII in the two C. sorokiniana transformants was analyzed by qRT-PCR (Fig. 4d). C. sorokiniana actin gene was used to normalize the expression patterns (Fig. 4e). The transformed lines with hptII transcript levels < 5-fold were categorized as low, while those with more than a fivefold increase in expression were considered as high expression lines. Among the transformed lines checked, the CsTr-16 line showed high expression (Fig. 4F). The wild-type line showed no expression of the hptII. However, no correlation was found between the hptII expression level and the transgene copy number in the transformants, which could be attributed to the position effects of the T-DNA integration sites (Gelvin 2003; Steinbrenner and Sandmann 2006; Liu et al. 2013). The integration of the hptII in the transcriptionally active locus of the CsTr-16 genome could have led to a higher expression of the hptII in the transformed line (Prasad et al. 2019; Gelvin 2003).
Expression of gus gene in C. sorokiniana transformed lines
The transformed lines were further subjected to Western blot analysis to detect GUS expression using anti-GUS antibodies. The whole-cell protein from wild-type cell lines was used as a negative control. An approximately 70-kDa band was observed in the protein samples of the transformants. In contrast, no such bands were observed in wild-type samples (Fig. 4g), confirming the active functionality of gus transgene in the two transformed lines of C. sorokiniana.
Growth profile of wild-type and genetically transformed C. sorokiniana
To evaluate the possible interference of transgene expression on growth and cellular metabolism of the genetically transformed C. sorokiniana cells, the specific growth rate, biomass doubling time, photosynthetic efficiency of PSII, and fatty-acid profile of transformed cells were compared with the wild-type untransformed cells. The results of this study (Figs. 5, 6) suggested that the transformants had a similar growth pattern and metabolic processes as that of wild-type cell lines, and the random integration of transgene had no adverse effect on growth and cellular metabolism. This finding was in correlation with previous reports (Prasad et al. 2019; Liu et al. 2013), which observed a similar growth pattern in the wild type and the transformants.
Growth rate and photosynthetic productivity-related parameters of transgenic (CsTr-9/16) and wild-type (Wt) cell lines of C. sorokiniana under optimal growth conditions. a Growth curve of C. sorokiniana cell lines; b Biomass productivity of the C. sorokiniana cell lines measured through dry cell weight (DCW); c Comparison of different photosynthetic parameters among transgenic (CsTr-9/16) and wild-type (Wt) cell lines of C. sorokiniana. d Transgenic (CsTr-9/16) and wild-type (Wt) cell lines of C. sorokiniana cultured in TAP liquid media for a period of 20 days
Triacylglycerol accumulation and Fatty acid profile of wild-type and transgenic C. sorokiniana cell lines. a TLC separation of neutral lipids: lane 1, trioleate standard; lanes 2–4, wild type, CsTr-9 and CsTr-16, respectively (cell lines cultured under nitrogen-sufficient conditions); lanes 5–7, wild type, CsTr-9 and CsTr-16, respectively (cell lines cultured under nitrogen-deficient conditions). Neutral lipid was fractioned by Silica Gel plates into triacylglycerol (TAG), free fatty acids (FFA) and diacylglycerol (DAG) fractions; b TAG content in wild-type (Wt), transgenic cell lines (CsTr-9 and CsTr-16) cultured under nitrogen-deficient conditions; c fatty acid (FA) profile of transgenic (CsTr-9 and CsTr-16) and wild-type (Wt) C. sorokiniana
Conclusion
To harness the benefit of microalgal biotechnology for biofuel application, genetic manipulation of metabolic pathways is essential, requiring an efficient genetic transformation method. Besides, an efficient gene transfer system in microalgae would allow a way to understand cellular metabolism regulation by characterizing the genes involved through a reverse genetics approach. A. tumefaciens-mediated genetic transformation is a method of choice for ease in transformation and for its ability to precisely integrate low copy number transgene into transcriptionally active genomic regions. However, in C. sorokiniana, the lack of a reliable and efficient Agrobacterium-mediated gene transfer method limits its potential uses in commercial-scale utilization. We described an efficient A. tumefaciens-mediated genetic transformation in C. sorokiniana. For the first time in C. sorokiniana, it highlighted the reliable detection of stable transgene integration and expression in C. sorokiniana, which opens up limitless possibilities in biofuel production and other commercially valuable commodities.
Furthermore, considering the crucial role of Agrobacterium vir gene induction on effective T-DNA transfer, we optimized crucial cocultivation conditions. We found cocultivation of C. sorokiniana cells (OD680 = 1.0), on BG11 agar medium with pH 5.6, supplemented with 100 μM of acetosyringone, for three days at 25 ± 2 °C in the dark, with Agrobacterium at a cell density of OD600 = 0.6 resulted in the efficient transformation of C. sorokiniana. Our finding opens up new possibilities for microalga with commercial potentials such as C. sorokiniana through genetic manipulation for specific target genes associated with diverse cellular pathways.
References
Anila N, Chandrashekar A, Ravishankar GA, Sarada R (2011) Establishment of Agrobacterium tumefaciens-mediated genetic transformation in Dunaliella bardawil. Eur J Phycol 46:36–44
Bajhaiya AK, Moreira JZ, Pittman JK (2017) Transcriptional engineering of microalgae: prospects for high-value chemicals. Trends Biotechnol 35:95–99
Bakshi S, Sadhukhan A, Mishra S, Sahoo L (2011) Improved Agrobacterium-mediated transformation of cowpea via sonication and vacuum infiltration. Plant Cell Rep 30:2281–2292
Barik DP, Mohapatra U, Chand PK (2005) Transgenic grasspea (Lathyrus sativus L.): factors influencing Agrobacterium-mediated transformation and regeneration. Plant Cell Rep 24:523–531
Barry AN, Starkenburg SR, Sayre RT (2015) Strategies for optimizing algal biology for enhanced biomass production. Front Energy Res 3:1
Bligh EG, Dyer WJ (1959) A rapid method of total lipid extraction and purification. Can J Biochem Physiol 37:911–917
Cha TS, Yee W, Aziz A (2012) Assessment of factors affecting Agrobacterium-mediated genetic transformation of the unicellular green alga Chlorella vulgaris. World J Microbiol Biotechnol 28:1771–1779
Chakrabarty R, Viswakarma N, Bhat SR, Kirti PB, Singh BD, Chopra VL (2002) Agrobacterium-mediated transformation of cauliflower: optimization of protocol and development of Bt-transgenic cauliflower. J Biosci 27:495–502
Cordero BF, Obraztsova I, Couso I, León R, Vargas MA, Rodríguez H (2011) Enhancement of lutein production in Chlorella sorokiniana (Chlorophyta) by improvement of culture conditions and random mutagenesis. Mar Drugs 9(9):1607–1624
Courchesne NM, Parisien A, Wang B, Lan CQ (2009) Enhancement of lipid production using biochemical, genetic and transcription factor engineering approaches. J Biotechnol 141:31–41
de Andrade CJ, de Andrade LM (2017) An overview on the application of genus Chlorella in biotechnological processes. J Adv Res Biotechnol 2:1–9
Dehghani J, Adibkia K, Movafeghi A, Pourseif MM, Omidi Y (2020) Designing a new generation of expression toolkits for engineering of green microalgae; robust production of human interleukin-2. Bioimpacts 10(4):259–268
Doron L, Segal N, Shapira M (2016) Transgene expression in microalgae—from tools to applications. Front Plant Sci 7:505
Gelvin SB (2003) Agrobacterium-mediated plant transformation: the biology behind the ‘Gene-Jockeying’ tool. Microbiol Mol Biol Rev 67:16–37
George J, Kahlke T, Abbriano RM, Kuzhiumparambil U, Ralph PJ, Fabris M (2020) Metabolic engineering strategies in diatoms reveal unique phenotypes and genetic configurations with implications for algal genetics and synthetic biology. Front Bioeng Biotechnol 8:513
Godoy-Hernandez G, Vázquez-Flota FA (2006) Methods in molecular biology. Plant Cell Cult Protoc 318:51–58
Gómez-Espinoza O, Garro-Monge G, Peraza J, Núñez-Montero K, Meneses-Montero K, Guerrero-Barrantes M (2018) Transformación genética de Chlorella sorokiniana mediada por Agrobacterium tumefaciens. Tecnología en Marcha 31(1):160–166
Gross DS, Collins KW, Hernandez EM, Garrard TW (1988) Vacuum blotting: a simple method for transferring DNA from sequencing gels to nylon membranes. Gene 74:347–356
Han X, Song X, Li F, Lu Y (2020) Improving lipid productivity by engineering a control-knob gene in the oleaginous microalga Nannochloropsis oceanic. Metab Eng Commun 11:e001422
He F (2011) Bradford protein assay. Bio 101:e45
Hoebeeck J, Speleman F, Vandesompele J (2007) Real-time quantitative PCR as an alternative to southern blot or fluorescence in situ hybridization for detection of gene copy number changes. In: Hilario E, Mackay J (eds) Protocols for nucleic acid analysis by nonradioactive probes, pp 205–226
Hu Z, Wu Y, Li W, Gao H (2006) Factors affecting Agrobacterium-mediated genetic transformation of Lycium barbarum L. in Vitro Cell Dev Biol Plant 42:461–466
Karami O (2008) Factors Affecting Agrobacterium-mediated transformation of plants. Transgenic Plant J 2:127–137
Kathiresan S, Chandrashekar A, Ravishankar GA, Sarada R (2009) Agrobacterium-mediated transformation of the green alga Haematococcus pluvialis (Chlorophyceae, Volvocales). J Phycol 45:642–649
Kumar SV, Misquitta RW, Reddy VS, Rao RJ, Rajam MV (2004) Genetic transformation of the green algae—Chlamydomonas reinhardtii by Agrobacterium tumefaciens. Plant Sci 166:731–738
Kumar S, Raja SK, Sharma AK, Varma HN (2012) Genetic transformation and development of Cucumber mosaic virus resistant transgenic plants of Chrysanthemum morifolium cv Kundan. Sci Hortic 134:40–45
Lee J-W, Lee M-W, Ha J-S, Kim D-S, Jin ES, Lee H-G, Oh H-M (2020) Development of a species-specific transformation system using the novel endogenous promoter calreticulin from oleaginous microalgae Ettlia sp. Sci Rep 10:13947
Liu J, Gerken H, Huang J, Chen F (2013) Engineering of an endogenous phytoene desaturase gene as a dominant selectable marker for Chlamydomonas reinhardtii transformation and enhanced biosynthesis of carotenoids. Proc Biochem 48:788–795
Malapascua JRF, Jerez CG, Sergejevová M, Figueroa FL, Masojídek J (2014) Photosynthesis monitoring to optimize growth of microalgal mass cultures: application of chlorophyll fluorescence techniques. Aquat Biol 22:123–140
Maravi DK, Kumar S, Sharma PK, Kobayashi Y, Goud VV, Sakurai N, Koyama H, Sahoo L (2016) Ectopic expression of AtDGAT1, encoding diacylglycerol O-acyltransferase exclusively committed to TAG biosynthesis, enhances oil accumulation in seeds and leaves of Jatropha. Biotechnol Biofuels 9:226
Merchant SS, Kropat J, Liu B, Shaw J, Warakanont J (2012) TAG, you’re it! Chlamydomonas as a reference organism for understanding algal triacylglycerol accumulation. Curr Opin Biotechnol 23:352–363
Mini P, Demurtas OC, Valentini S, Pallara P, Aprea G, Ferrante P, Giuliano G (2018) Agrobacterium-mediated and electroporation-mediated transformation of Chlamydomonas reinhardtii: a comparative study. BMC Biotechnol 18:11
Murray HG, Thompson WF (1980) Rapid isolation of high molecular weight DNA. Nucleic Acids Res 8:4321–4325
Naidoo RK, Simpson ZF, Oosthuizen JR, Bauer FF (2019) Nutrient exchange of carbon and nitrogen promotes the formation of stable mutualisms between Chlorella sorokiniana and Saccharomyces cerevisiae under engineered synthetic growth conditions. Front Microbiol 10:609
Naing AH, Ai TN, Jeon SM, Lim SH, Kim CK (2016) An efficient protocol for Agrobacterium-mediated genetic transformation of recalcitrant chrysanthemum cultivar Shinma. Acta Physiol Plant 38:38
Ng IS, Tan SI, Kao PH, Chang YK, Chang JS (2017) Recent developments on genetic engineering of microalgae for biofuels and bio-based chemicals. Biotechnol J 12:1600644
Pfaffl MW (2006) Relative quantification. In: Dorak MT (ed) Real-time PCR, pp 63–82
Prasad B, Nithya V, Jeong HJ, General T, Cho M-G, Lein W (2014) Agrobacterium tumefaciens-mediated genetic transformation of haptophytes (Isochrysis species). Appl Microbiol Biotechnol 98:8629–8639
Prasad B, Lein W, Thiyam G, Lindenberger CP, Buchholz R, Vadakedath N (2019) Stable nuclear transformation of rhodophyte species Porphyridium purpureum: advanced molecular tools and an optimized method. Photosynth Res 140:173–188
Pratheesh PT, Vineetha M, Kurup GM (2014) An efficient protocol for the Agrobacterium-mediated genetic transformation of microalga Chlamydomonas reinhardtii. Mol Biotechnol 56:507–515
Pribyl P, Cepak V, Zachleder V (2012) Production of lipids in 10 strains of Chlorella and Parachlorella, and enhanced lipid productivity in Chlorella vulgaris. Appl Microbiol Biotechnol 94:549–561
Radakovits R, Jinkerson RE, Darzins A, Posewitz MC (2010) Genetic engineering of algae for enhanced biofuel production. Eukaryot Cell 9:486–501
Randhawa KS, Relph LE, Armstrong MC, Rahman PKSM (2017) Biofuel production: tapping into microalgae despite challenges. Biofuels 8:261–271
Rathod JP, Prakash G, Pandit R, Lali AM (2013) Agrobacterium-mediated transformation of promising oil-bearing marine algae Parachlorella kessleri. Photosynth Res 118:141–146
Rosenberg JN, Kobayashi N, Barnes A, Noel EA, Betenbaugh MJ, Oyler GA (2014) Comparative analyses of three Chlorella species in response to light and sugar reveal distinctive lipid accumulation patterns in the microalga C. sorokiniana. PLoS ONE 9:e92460
Sanitha M, Radha S, Fatima AA, Devi SG, Ramya M (2014) Agrobacterium-mediated transformation of three freshwater microalgal strains. Pol J Microbiol 63:387–392
Schmittgen TD, Livak KJ (2008) Analyzing real-time PCR data by the comparative CT method. Nat Protoc 3:1101–1108
Shaikh KM, Nesamma AA, Abdin MZ, Jutur PP (2019) Molecular profiling of an oleaginous trebouxiophycean alga Parachlorella kessleri subjected to nutrient deprivation for enhanced biofuel production. Biotechnol Biofuels 12:182
Sharma KK, Schuhmann H, Schenk PM (2012) High lipid induction in microalgae for biodiesel production. Energies 5:1532–1553
Sharma PK, Saharia M, Srivastava R, Kumar S, Sahoo L (2018) Tailoring microalgae for efficient biofuel production. Front Mar Sci 5:382
Srinivasan R, Gothandam KM (2016) Synergistic action of d-glucose and acetosyringone on Agrobacterium strains for efficient Dunaliella transformation. PLoS ONE 11:e0158322
Stanier RY, Kunisawa R, Mandel M, Cohen-Bazire G (1971) Purification and properties of unicellular blue-green algae (order Chroococcales). Bacteriol Rev 35:171–205
Steinbrenner J, Sandmann G (2006) Transformation of the green alga Haematococcus pluvialis with a phytoene desaturase for accelerated astaxanthin biosynthesis. Appl Environ Microbiol 72:7477–7484
Sueoka N (1960) Mitotic replication of deoxyribonucleic acid in Chlamydomonas reinhardi. Proc Natl Acad Sci USA 46:83–91
Suttangkakul A, Sirikhachornkit A, Juntawong P, Puangtame W, Chomtong T, Srifa S, Sathitnaitham S, Dumrongthawatchai W, Jariyachawalid K, Vuttipongchaikij S (2019) Evaluation of strategies for improving the transgene expression in an oleaginous microalga Scenedesmus acutus. BMC Biotechnol 19:4
Weis VM, Verde EA, Reynolds WS (2002) Characterization of a short form peridinin-chlorophyll-protein (PCP) cDNA and protein from the sea anemone Anthopleura Elegantissima (Cnidaria). J Phycol 38:157–163
Wise AA, Liu Z, Binns AN (2006) Culture and maintenance of Agrobacterium strains. Methods Mol Biol 343:3–13
Zhu Q, Wu F, Ding F, Ye D, Chen Y, Li Y, Zhifan Y (2009) Agrobacterium-mediated transformation of Dioscorea zingiberensis Wright, an important pharmaceutical crop. Plant Cell Tissue Organ Cult 96:317–324
Zhu BH, Shi HP, Yang GP, Lv NN, Yang M, Pan KH (2016) Silencing UDP-glucose pyrophosphorylase gene in Phaeodactylum tricornutum affects carbon allocation. New Biotechnol 33:237–244
Zienkiewicz K, Du ZY, Ma W, Vollheyde K, Benning C (2016) Stress-induced neutral lipid biosynthesis in microalgae—molecular, cellular and physiological insights. Biochim Biophys Acta (BBA) Mol Cell Biol Lipids 1861:1269–1281
Acknowledgements
The work was supported by the Department of Biotechnology, Government of India for the research Grant (BT/PR13560/COE/34/44/2015) to LS. The fellowship (JRF and SRF) to PKS by MHRD is greatly acknowledged.
Author information
Authors and Affiliations
Contributions
LS conceived the work. LS, VVG, and YY designed the experiments. PKS conducted all the experiments. LS, YY and VVG critically analyzed the data. LS prepared the manuscript. YY and VVG corrected the manuscript. All authors read and approved the final manuscript.
Corresponding author
Ethics declarations
Conflict of interest
The authors declare that the research was conducted in the absence of any commercial or financial relationships that could be construed as a potential conflict of interest.
Consent for publication
All authors have approved the submission of the manuscript to 3 Biotech.
Supplementary Information
Below is the link to the electronic supplementary material.
13205_2021_2750_MOESM1_ESM.tif
Supplementary file1 Fig. S1 Preliminary test for Agrobacterium contamination in C. sorokiniana by culturing in YEP medium. Lane EHA105, A. tumefaciens strain EHA105; lane Wt, wild type; lane CsTr-9 and CsTr-16, transgenic C. sorokiniana cell lines; lane Blank, negative control (TIF 6592 KB)
Rights and permissions
About this article
Cite this article
Sharma, P.K., Goud, V.V., Yamamoto, Y. et al. Efficient Agrobacterium tumefaciens-mediated stable genetic transformation of green microalgae, Chlorella sorokiniana. 3 Biotech 11, 196 (2021). https://doi.org/10.1007/s13205-021-02750-7
Received:
Accepted:
Published:
DOI: https://doi.org/10.1007/s13205-021-02750-7